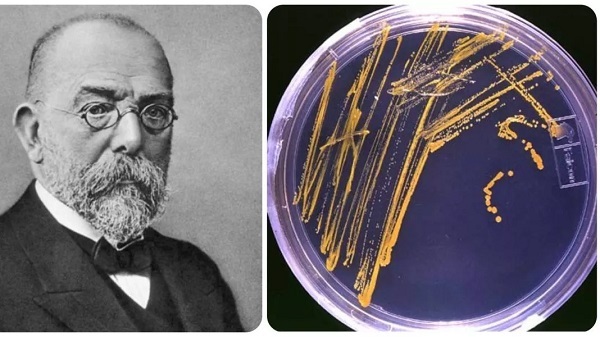
۱۱ خرداد در دنیای علم چه خبر؟ ۱۱ خرداد در دنیای علم چه خبر؟

۱۱ خرداد در دنیای علم چه خبر؟
به گزارش خبرگزاری علم و فناوری آنا،تاریخ علم مملو از رویدادهای مهمی است که نوآوریها، کشفها و حتی زادروزها و درگذشتهای دانشمندان و مخترعان تاثیرگذار جهان را در برمیگیرد. در این تقویم علم، وقایع مهم مصادف با امروز ۱۱ خرداد برابر ۳۱ می را ورق میزنیم.
***
روسازی آسفالت
۳۱ می ۱۸۷۰ میلادی برابر با ۱۱ خرداد ۱۲۴۹ خورشیدی، استاد دانشگاه کلمبیا ادوارد جی. دو اسمِت، حق ثبت اختراع ایالاتمتحده را برای ورقههای روسازی آسفالت دریافت کرد. این اختراع بهعنوان روکش آسفالت فرانسوی شناخته میشد زیرا نخستینبار از آن در سال ۱۸۵۴ در پاریس استفاده شد. این ترکیب از مخلوطکردن شن و ماسه با آسفالت طبیعی بود که حدود ۷ بخش آن از ماسه بسیار سفت تشکیل میشد. اما دو اسمت مخلوطی به نسبت ۵ به ۱ ساخت که با روغنهای نفتی خاص و ذرات معدنی روان میشد و کار با آن آسانتر بود. در این ترکیب، روی یک سطح جاده درجهبندیشده یک لایه ماسه داغ نیماینچی همراه با یک لایه یکاینچی مخلوط آسفالت داغ و ماسه گذاشته میشد و این لایهها با غلتک داغ فشرده میشد. این فرآیند برای ایجاد پوشش ضخیمتر جاده تکرار میشد.
کشف تصادفی گور-دخمههای رم
۳۱ می ۱۵۷۸ میلادی برابر با ۱۱ خرداد ۹۵۷ خورشیدی، گور-دخمههای رم بهطور تصادفی کشف شد. چند کارگر که برای استخراج خاک پوزولان حفاری میکردند ورودیهای یکی از این دخمهها را بازکردند. بارونیوس مورخ کلیسا یکی از اولین کسانی بود که از این کشف جدید بازدید کرد. پانزده سال بعد، در دسامبر ۱۵۹۳، جوان ۱۸ سالهای بهنام آنتونیو بوزیو کاوش در این دخمهها را آغاز کرد. کاری که کل دوران حیاتش را دربرگرفت. او بهتدریج پیوندهایی بین دخمهها پیدا کرد، زیرا گذرگاههای باریکی از یک دخمه به دخمه دیگر حفر شده بود. بهاینترتیب، او موفق شد ۳۰ ورودی دیگر را پیدا کند و آنچه را که پیدا کرده بود با دقت با مراقبت یک باستانشناس ثبت کرد. این دخمهها مربوط به قرن سوم است که در آن زمان توسط مسیحیان رم استفاده میشد، زیرا در آن دوران، دفع مردگان پیروان مسیحیت در گورستانهای عادی ممنوع بود.

الیزابت بلکوِل
۳۱ می ۱۹۱۰ میلادی برابر با ۱۱ خرداد ۱۲۸۹ خورشیدی، الیزابت بلکول، پزشک انگلیسیآمریکایی درگذشت. او اولین زنی است که در دوران معاصر دکترای پزشکی گرفت و اولین زنی است که مدرکش را از دانشکده پزشکی در ایالات متحده گرفت. بسیاری از پزشکان قرن نوزدهم، ازجمله چند زن، بدون مدرک طبابت میکردند، اما بلکول آرزوی موقعیت حرفهای مطلوبی را داشت و درحالیکه از سوی تمام دانشکدههای اصلی پزشکی کشور به دلیل جنسیتش رد شد، درخواستش برای دانشکده پزشکی ژنو (اکنون کالجهای هوبارت و ویلیام اسمیت در ژنو، نیویورک) به هیئت دانشجویی ارجاع شد. آنها با خنده بسیار پذیرفتند و فکر کردند که این درخواستی دروغین از یک مدرسه پزشکی رقیب است اما همین پذیرش باعث شد او به دانشکده پزشکی راه یابد و با عزمی راسخ کار کند و با تلاش بسیار بتواند دشمنی استادان، دانشجویان و مردم شهر را کنار بزند. او مدرک پزشکیاش را در سال ۱۸۴۹ دریافت کرد.

یولیوس ریشارد پتری
۳۱ می ۱۸۵۲ میلادی برابر با ۱۱ خرداد ۱۲۳۱ خورشیدی، یولیوس ریشارد پتری، پزشک و باکتریشناس آلمانی بهدنیا آمد. او را بهدلیل نامی که به ظرف پتری دادهاند بهیاد میآورند. ظرف پتری، ظرفی کمعمق و استوانهای است که از پلاستیک یا شیشه با روکش ساخته شده و برای کشت بافت و نگهداری محیط جامد برای کشت و زیرکشت باکتریها استفاده میشود. پتری آن را برای تکنیک شبیهسازی سویههای باکتری با استفاده از شیب آگار و کشت فرعی در خود ظرف و شناسایی کلونیهای مختلف باکتری توسعه داد. او این ابزار آزمایشگاهی را زمانی اختراع کرد که بهعنوان دستیار رابرت کخ، باکتریشناس معروف آلمانی و کاشف عامل بیماری سل، کار میکرد.
انتهای پیام/